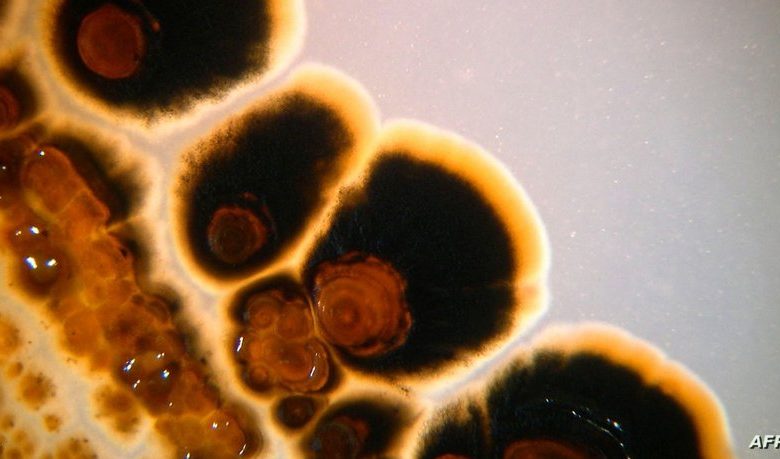

بعد وباء فيروس كورونا، بدأ الأطباء يشخصون سرطانات غير عادية ونادرة لدى أشخاص من مختلف الأعمار، ما أعاد فكرة معروفة لدى خبراء الصحة أن الفيروسات يمكن أن تسبب ظهور السرطان أو تعيده بسرعة إلى الواجهة.
وينقل تقرير من صحيفة “واشنطن بوست” عن الطبيب كاشياب باتيل أنه في عام 2021، أي بعد عام من وباء كورونا، شخّص مريضا في الأربعينيات من عمره بسرطان القنوات الصفراوية، وهو سرطان نادر ومميت في القنوات الصفراوية يصيب عادة الأشخاص في عمر 70 و 80 عاما.
وعندما أخبر باتيل زملاءه بذلك، بدأوا أيضا يكشفون أنهم عالجوا مؤخرا مرضى لديهم تشخيصات مماثلة. وفي غضون سنة من ذلك الاجتماع، سجل المستشفى سبع حالات من هذا القبيل.
ويتذكر باتيل، الرئيس التنفيذي لشركة “Carolina Blood and Cancer Care Associates، “أمارس الطب لمدة 23 عاما ولم أرى شيئا كهذا من قبل”، ويوافقه الرأي أسوتوش غور، وهو طبيب أورام آخر: “لقد هزتنا جميعا”. كانت هناك غرابة أخرى أيضا: العديد من المرضى الذين يتعاملون مع أنواع متعددة من السرطان تنشأ في وقت واحد تقريبا ، وأكثر من اثنتي عشرة حالة جديدة من السرطانات النادرة الأخرى.
تم تأكيد الارتفاع في السرطانات العدوانية في المراحل المتأخرة منذ الوباء من خلال بعض البيانات الوطنية المبكرة وعدد من مؤسسات السرطان الكبيرة، وفق التقرير.
وفكرة أن بعض الفيروسات يمكن أن تسبب السرطان أو تسرعه ليست جديدة. لقد أدرك العلماء هذا الاحتمال منذ ستينيات القرن العشرين ، واليوم، يقدر الباحثون أن 15 إلى 20 في المئة من جميع أنواع السرطان في جميع أنحاء العالم تنشأ من عوامل معدية مثل فيروس الورم الحليمي البشري والتهاب الكبد B.
من المحتمل أن تمر سنوات عديدة قبل أن يحصل العالم على إجابات قاطعة حول ما إذا كان فيروس كورونا وراء زيادة حالات السرطان ، لكن باتيل وغيره من العلماء المعنيين يدعون الحكومة الأميركية إلى جعل هذا السؤال أولوية مع العلم أنه يمكن أن يؤثر على علاج وإدارة ملايين مرضى السرطان لعقود قادمة.
ولا توجد بيانات حقيقية تربط كورونا بالسرطان، ولا يزال بعض العلماء متشككين. وقال جون تي شيلر، الباحث في المعاهد الوطنية للصحة والرائد في دراسة الفيروسات المسببة للسرطان، إن مسببات الأمراض المعروفة بأنها تسبب السرطان تستمر في الجسم على المدى الطويل. لكن فئة فيروسات الجهاز التنفسي التي تشمل الإنفلونزا وكورونا تصيب المريض ثم تختفي عادة بدلا من البقاء ولا يعتقد أنها تسبب السرطان.
وقال ديفيد توفيسون، مدير مركز السرطان في مختبر كولد سبرينج هاربور والرئيس السابق للجمعية الأميركية لأبحاث السرطان، إنه لا يوجد دليل على أن فيروس كورونا يحول الخلايا مباشرة لجعلها سرطانية. لكن قد لا تكون هذه هي القصة الكاملة.
وأوضح توفيسون أن عددا من الدراسات الصغيرة والمبكرة، التي نشر الكثير منها خلال الأشهر التسعة الماضية، تشير إلى أن عدوى فيروس كورونا يمكن أن تحفز سلسلة التهابية واستجابات أخرى يمكن أن تؤدي، من الناحية النظرية، إلى تفاقم نمو الخلايا السرطانية.
تفسيرات
ويضيف توفيسون: “كوفيد يدمر الجسم، وهذا هو المكان الذي يمكن أن تبدأ فيه السرطانات”.
وحتى عندما ضربت الموجة الأولى من فيروس كورونا الولايات المتحدة، توقع مسؤولو الصحة العامة زيادة في حالات السرطان. وحللت ورقة من مجلة “لانسيت” للأورام سجلا وطنيا يظهر زيادات في تشخيص المرحلة 4 الأكثر حدة من أنواع السرطان في أواخر عام 2020.
وأصدر معهد الصحة المعمدانية في ميامي للسرطان وجامعة كاليفورنيا في سان دييغو هيلث وغيرها من المؤسسات الكبيرة بيانات تظهر الزيادات المستمرة في السرطانات في المراحل المتأخرة.
وعزا شيوسونغ هان، المدير العلمي لأبحاث الخدمات الصحية في جمعية السرطان الأميركية والمؤلف الرئيسي لدراسة “لانسيت” للأورام، هذه القفزة إلى تأخر بعض الناس في طلب الرعاية بسبب المخاوف المتعلقة بالفيروس أو لأسباب اقتصادية.
ويدرس فريق من جامعة كولورادو ما إذا كان كوفيد يوقظ الخلايا السرطانية الخاملة في الفئران. وأظهرت النتائج التي توصل إليها، وفقا لتقرير ما قبل النشر صدر في أبريل، أنه عندما أصيبت الفئران الناجية من السرطان بفيروس كورونا تكاثرت الخلايا السرطانية الخاملة في الرئتين، وتوصلوا إلى نتائج مماثلة مع فيروس الأنفلونزا.
وقالت أشاني ويراراتنا، الأستاذة في كلية جونز هوبكنز بلومبرغ للصحة العامة، إن دراسة كولورادو، التي لم تشارك فيها، هي جزء من مجال عمل جديد ظهر خلال العقد الماضي والذي يتعمق في المحفزات التي يمكن أن توقظ الخلايا السرطانية.
متابعات